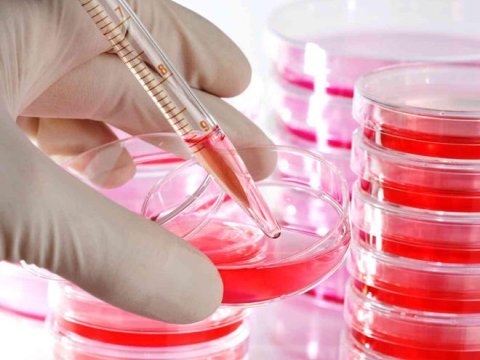
Bakı və Sumqayıtda&nbsp;hemofiliyalı xəstələrin sayı artıb

2025
Dekabr
Rusiyada azərbaycanlılara HÜCUMLAR - Kreml yenidən diş qıcayır
-
09:32, Bu günŞahramanyan istintaqa çağırıdı
-
09:24, Bu günDağlıq yollarda hərəkət edən sürücülərə xəbərdarlıq
-
09:20, Bu günAbbas Abbasov axtarışa verildi
-
09:08, Bu günXarici valyutaların manata qarşı MƏZƏNNƏLƏRİ
-
09:04, Bu günDeputatlar yenidən toplaşır - Gündəlikdə 10 məsələ var
-
09:00, Bu günTovuzda 14 yaşlı qızı ərə vermək istədilər
-
08:59, Bu günFHN 20 ildir xilas edir!
-
08:55, Bu günABŞ Sakit okeanda narkotik daşıyan üç kateri vurub: Ölənlər var
-
08:48, Bu günBiləsuvarda elektrik fasiləsi - Xırmandalıda işıq olmayacaq!
-
08:41, Bu günAzadlıq heykəli güclü küləyə tab gətirə bilmədi - VİDEO
-
08:38, Bu günDünyanın ən böyük kruiz gəmi "qəbiristanlığı" Türkiyədə aşkarlanıb
-
08:38, Bu günBir reklama görə 45 milyon qazanacaq
-
08:34, Bu günTıxacda qalmaq istəməyənlər oxusun - SİYAHI
-
08:19, Bu gün21 ailə üçün yeni il, yeni həyat Sos kəndində başlayacaq!
-
08:16, Bu günTramp BBC-ni məhkəməyə verib
-
00:52, Bu günAvropa ölkəsi NATO-ya üzv olmağı düşünür
-
00:40, Bu günÇoxsaylı məsələlərdə irəliləyiş əldə olundu - ZELENSKİ
-
00:22, Bu günMüəllimi pis, repetitoru isə yaxşı göstərmək məntiqsizdir - Nazir
-
00:10, Bu günQərb Xəzər beşliyini parçalamağa çalışır - LAVROV
-
15 Dekabr 2025, 23:52Zakir Qaralova ağır itki
-
15 Dekabr 2025, 23:40Məktəbləri bağlamaqla fəxr etmirik - Emin Əmrullayev
-
15 Dekabr 2025, 23:23İranda zavod partladı - 9 nəfər öldü
-
15 Dekabr 2025, 23:01Tələbə yerdəki 100 manatı götürərkən yıxılıbmış
-
15 Dekabr 2025, 22:50Ukraynadan unikal əməliyyat - Rusiyanın sualtı gəmisi məhv edildi
-
15 Dekabr 2025, 22:34Gələn il Qarabağ Universitetində neçə tələbə oxuyacaq?
-
15 Dekabr 2025, 22:16Türkiyəyə naməlum dron yaxınlaşdı - Qırıcılar havada vurdu - TƏCİLİ
-
15 Dekabr 2025, 22:08“Müəllim” sözünü düzgün yaza bilməyən müəllimlər... - NAZİR
-
15 Dekabr 2025, 21:51Gizir Xanıya şəhidlik statusu verildi
-
15 Dekabr 2025, 21:40Anar Ələkbərov Ramiz Rövşəni evində ziyarət etdi
-
15 Dekabr 2025, 21:36Azərbaycanda məktəblər distant təhsilə keçə bilər